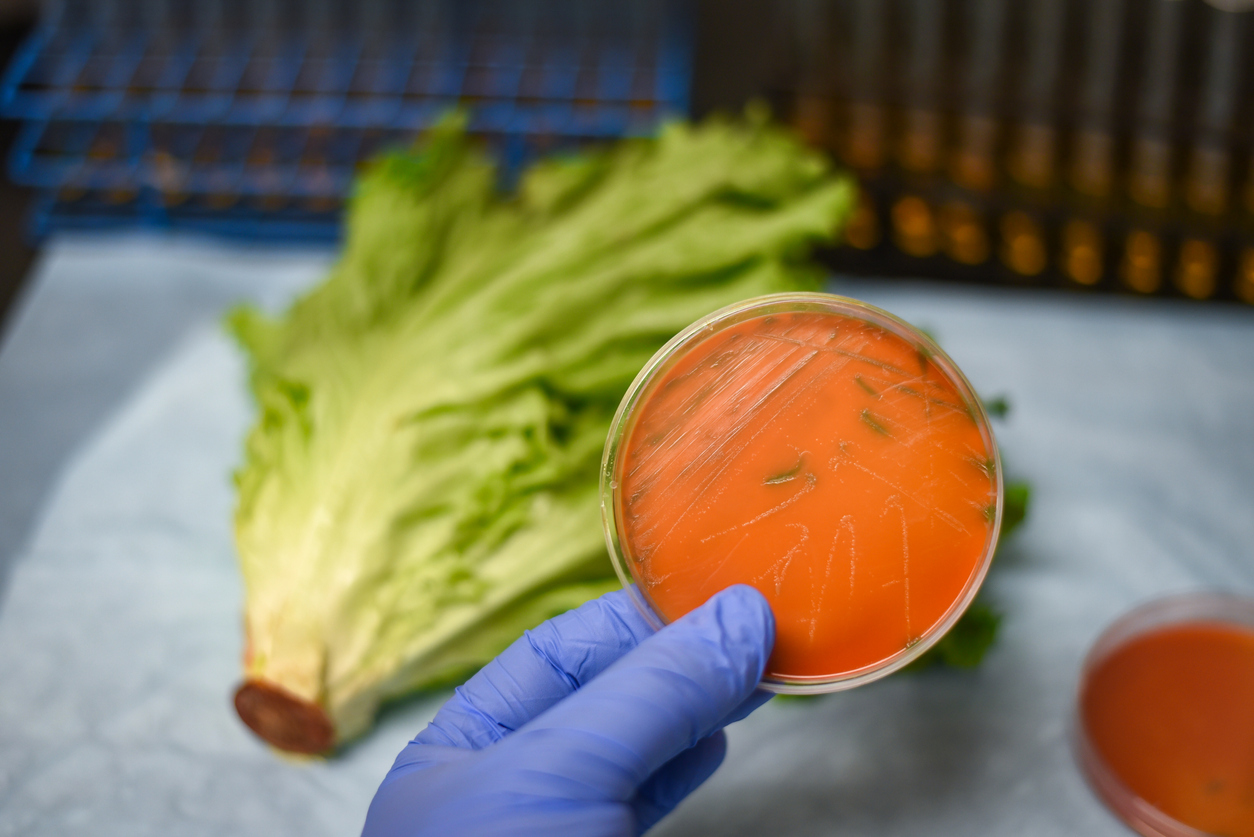

Ορισμένοι ιοί, βακτήρια και παράσιτα είναι καλοήθη για τη μητέρα, αλλά, παρόντα στο αίμα, μπορούν να διασχίσουν τον φραγμό του πλακούντα και να φτάσουν στο αγέννητο μωρό.
Αυτό συμβαίνει με τη λιστερίωση και την τοξοπλάσμωση, αντίστοιχα, ένα βακτήριο και ένα παράσιτο, ακίνδυνο για τη μητέρα αλλά επικίνδυνο για το έμβρυο.
Ποια τρόφιμα πρέπει να αποφεύγετε κατά τη διάρκεια της εγκυμοσύνης για να τα αποτρέψετε;

Τι είναι η λιστερίωση;
Η λιστέρια είναι βακτηρίδιο και είναι ευρέως διαδεδομένη στο περιβάλλον. Tα τρόφιμα είναι η κυριότερη πηγή λοίμωξης. Το πρόβλημα με τα μολυσμένα τρόφιμα εντείνεται από το γεγονός ότι οι λιστέριες έχουν τη δυνατότητα να πολλαπλασιάζονται σε θερμοκρασίες ψυγείου και είναι ανθεκτικές σε συντηρητικές ουσίες και σε αρκετά χαμηλό pH.
O χρόνος επώασης της νόσου κυμαίνεται από 1 έως 70 ημέρες, με μέσο όρο τις 3 εβδομάδες. Περίπου το 1/3 των περιπτώσεων λιστερίωσης αφορούν τις έγκυες γυναίκες και τα νεογνά. Ωστόσο, η μόλυνση με λιστέρια στις έγκυες γυναίκες είναι πολύ σπάνια και μολύνεται μόλις μια στις 20.000 εγκυμονούσες.
Στην έγκυο γυναίκα η λιστερίωση εμφανίζεται συνήθως κατά το τρίτο τρίμηνο της εγκυμοσύνης.
Στις περισσότερες περιπτώσεις η μητέρα εμφανίζει μία ελαφρά εμπύρετη νόσο που μοιάζει με γριππώδες σύνδρομο Το έμβρυο μολύνεται μέσω του πλακούντα ή κατά τον τοκετό.
Η λιστερίωση των νεογνών εμφανίζεται είτε ως πρώιμη μορφή, συνήθως κατά τις 4 πρώτες ημέρες της ζωής του νεογνού, που χαρακτηρίζεται από σηψαιμία, πνευμονία, διάρροια, νευρολογικά συμπτώματα, εξάνθημα, με θνητότητα που φτάνει το 75%, είτε ως όψιμη μορφή, που εμφανίζεται σε τελειόμηνα νεογνά, τα οποία ενδεχομένως φαίνονται υγιή κατά τη γέννηση και εκδηλώνεται κατά την 7η ημέρα της ζωής τους, συνήθως ως μηνιγγίτιδα ή ως σηψαιμία. Η πρόγνωση είναι καλύτερη σε σχέση με την πρώιμη μορφή και 75% των νεογνών επιζούν.
Η πρόληψη της λιστερίωσης
Αυτό το βακτήριο είναι αρκετά κοινό: ανιχνεύεται σε μία στις διακόσιες έγκυες γυναίκες.
Εάν ανιχνευθεί εγκαίρως, η αντιβιοτική θεραπεία βοηθά στην προστασία του εμβρύου. Η λιστερίωση μπορεί να οδηγήσει σε μηνιγγίτιδα, αλλά μπορεί επίσης και να μολύνει τα μάτια και την καρδιά του μωρού.
Η αποφυγή ορισμένων τροφών κατά τη διάρκεια της εγκυμοσύνης βοηθά στην προστασία από λιστερίωση.
Ποια είναι λοιπόν αυτά τα τρόφιμα;
Τρόφιμα που πρέπει να αποφεύγετε κατά της λιστερίωσης:
- Νωπό γάλα και όλα τα τυριά νωπού γάλακτος.
- Τον ωμό φλοιό των τυριών, όπως από το Camembert ή το Brie.
- Ωμό ή άψητο κρέας και ψάρι.
- Ορισμένα αλλαντικά, όπως πατέ, φουά γκρα και προϊόντα σε μορφή ζελέ.
- Καπνιστό ψάρι, σουρίμι, ταραμά.
- Ωμά οστρακοειδή.
- Ωμά λαχανικά που δεν έχουν πλυθεί.
- Ακατέργαστοι σπόροι όπως η σόγια.
Τι είναι η τοξοπλάσμωση;
Το τοξόπλασμα είναι ένα ενδοκυττάριο παράσιτο που αποικίζει σχεδόν όλους τους ιστούς. Ιδιαίτερη προτίμηση δείχνει στο μυϊκό ιστό, στο εντερικό επιθήλιο και στον νευρικό ιστό. Μέσα στο κύτταρο το πρωτόζωο συνήθως ζει στο κυτταρόπλασμα.
Το τοξόπλασμα μεταδίδεται στον άνθρωπο κυρίως από το μολυσμένο χώμα και νερό και συνήθως υπεύθυνη είναι η γάτα που νοσεί και μολύνει το χώμα και το νερό με τα κόπρανά της.
Σπάνια ο άνθρωπος είναι δυνατό να μολυνθεί από τοξόπλασμα τρώγοντας κακοψημένο κρέας κάποιου μολυσμένου θηλαστικού. Όσον αφορά την εγκυμοσύνη, ο διαπλακουντιακός τρόπος μετάδοσης του τοξοπλάσματος και η παρεπόμενη συγγενής λοίμωξη, χρήζουν ιδιαίτερης προσοχής.
Η οξεία πρωτοπαθής τοξοπλάσμωση, κατά τη διάρκεια της εγκυμοσύνης, οδηγεί σε διασπορά του τοξοπλάσματος στον πλακούντα και σε μόλυνση του εμβρύου. Ο κίνδυνος προσβολής του κυήματος αυξάνει στο δεύτερο και ιδιαίτερα στο τρίτο τρίμηνο της κύησης.
Ανάλογα με την ηλικία της κύησης που έγινε η μόλυνση, είναι δυνατό να παρουσιαστούν προσβολή του νευρικού συστήματος, των σπλάχνων, των οφθαλμών, πρόωρος τοκετός ή ενδομήτριος θάνατος του εμβρύου. Αν το νεογνό επιζήσει, στα χρόνια που ακολουθούν εμφανίζονται οι νευρολογικές και ψυχοκινητικές διαταραχές της νόσου που οδηγούν σε καθυστέρηση της ανάπτυξης και τύφλωση.

Η πρόληψη της τοξοπλάσμωσης
Ορισμένες γυναίκες δεν έχουν ανοσία στην τοξοπλάσμωση (μία στις δύο έγκυες γυναίκες). Αυτή η κατάσταση ανιχνεύεται κατά τη διάρκεια της πρώιμης εγκυμοσύνης στο αίμα.
Σε περίπτωση μη ανοσοποίησης, πραγματοποιείται έλεγχος κάθε μήνα. Εάν εντοπιστεί το παράσιτο, συνταγογραφείται αντιβιοτική θεραπεία για την πρόληψη της μόλυνσης του μωρού. Να θυμάστε ότι η τοξοπλάσμωση μπορεί να προκαλέσει αποβολή ή να διαταράξει την ανάπτυξη του εμβρύου.
Πρέπει να ληφθούν ορισμένες προφυλάξεις για να αποφευχθεί η μόλυνση:
- Να πλένετε τα χέρια σας μετά την επαφή με το χώμα (το καλύτερο είναι να αποφύγετε την κηπουρική ή έστω να φοράτε ειδικά γάντια). Το ίδιο ισχύει όταν έρχεστε σε επαφή με ωμό κρέας.
- Μην αλλάζετε την αμμολεκάνη της γάτας.
Παράλληλα, θα πρέπει να αποφεύγονται ορισμένα τρόφιμα, όπως:
- Ωμά ή άψητα κρέατα.
- Καπνιστά ή μαριναρισμένα θηράματα.
- Ωμά μαλάκια.
- Λαχανικά, φρούτα και αρωματικά βότανα που τρώγονται ωμά και τα οποία δεν έχουν πλυθεί καλά.






